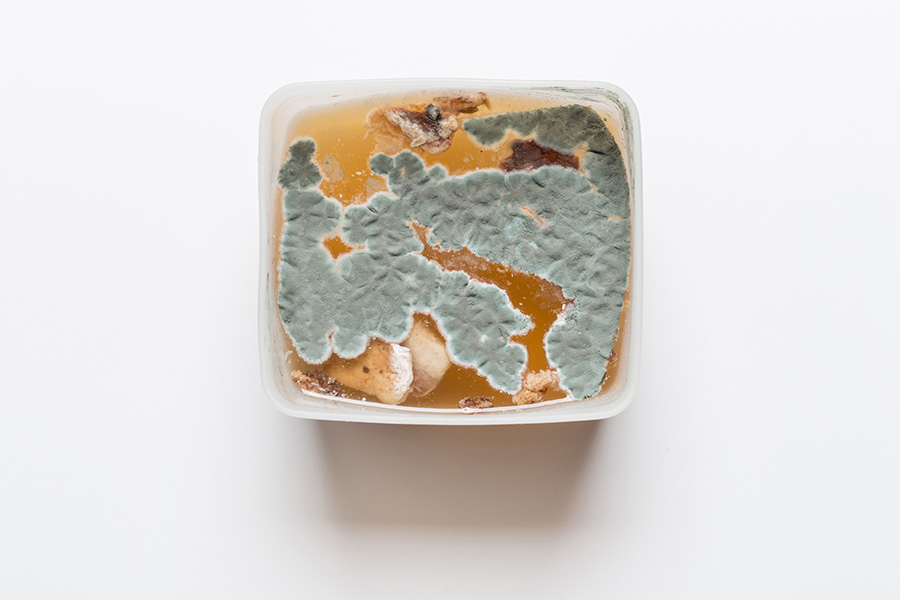

Naître – Vivre – Pourrir
La vie et la matière à l’épreuve, observer leurs altérations, les consigner ; laisser oxyder, brûler, lessiver, trancher le matériau corporel, de la chair végétale au départ, animale par la suite.
Une esthétique proche des Vanités parce que l’une des caractéristiques de l’organique est d’être vain : naître – vivre – pourrir.
_